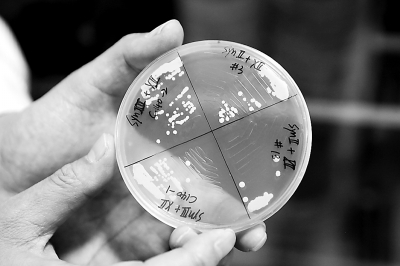

人类能否创造生命?“上帝”的特权能否交由人类自己掌控?
北京时间8月2日凌晨,国际顶级学术期刊《自然》(Nature)同时在线发表了2篇将酵母染色体融合的成果。其中一篇来自酵母染色体人工合成领域“老将”、美国科学院院士、纽约大学医学院教授杰夫o博克(Jef Boeke)团队,另一篇则来自中国科学院分子植物科学卓越创新中心/植物生理生态研究所合成生物学重点实验室覃重军研究团队及其合作者。
中国研究成果的通讯作者之一、植物生理生态研究所研究员、中国科学院院士赵国屏对澎湃新闻(www.thepaper.cn)表示,“这是继上世纪六十年代人工合成胰岛素和tRNA之后,中国学者再一次用合成科学的方法,回答了一个生命科学领域十分基础而重大的问题。”

基因组层面上化学合成生命的大门在2010年正式开启。当年,曾领衔人类基因组计划的美国科学家克莱格o文特尔(J. Craig Venter)及其团队在《科学》(Science)杂志报道了世界上首个“人造生命”——含有全人工化学合成的与天然染色体序列几乎相同的原核生物支原体,引起轰动。
2014年开始,美国、中国、英国、法国的研究团队将“人造生命”的目标从原核细菌跳跃至真核的酵母。截至2017年3月,已公开发表的成果显示,酵母的16条染色体已人工合成了6条。按照计划,科学家们将于2018年年底完成全部16条染色体的合成。
基于酵母可被人工设计的成熟度越来越高,围绕其展开的研究课题也逐渐多元化。
值得一提的是,由中国科学家独立完成的这项研究,是在国际上首次人工创建了单条染色体的真核细胞。同期发表的杰夫o博克团队成果则最终只能将16条酵母染色体融合至2条,尽管经过了很多次的尝试,杰夫o博克团队始终无法获得存活的、仅有一条染色体的细胞。
中科院深圳先进技术研究院合成生物学研究所(筹)副所长、深圳市合成生物学协会常务副会长戴俊彪在接受澎湃新闻采访时对研究成果点评道,“这是人类首次通过实验手段,实现对一个物种的染色体数目进行系统和大规模的改造。”戴俊彪未参与此项研究。
戴俊彪表示,包括杰夫o博克团队在内的两篇论文的研究结果均表明,自然进化而成的现有真核生物(至少酿酒酵母)染色体数目与功能之间并不存在直接的决定关系,染色体的数目可以进行人为的改变,同时对细胞生长不造成显著的影响。
大胆猜想:1条线型染色体装载所有遗传物质
在自然界漫长的进化过程中,不同生命体逐渐形成了自身特有的基因组,包括相对较为稳定的DNA序列和固定的染色体数目。
染色体携带了生命体生长与繁殖的遗传信息。染色体裸露无核膜包裹的原核生物通常含有环型结构的一条染色体,而染色体细胞核被核膜包裹的真核生物中,除了雄性杰克跳蚁(Myrmecia pilosula)只含一条染色体,其他所有已知的真核生物都包含数目不等的多条染色体。
然而,一些基本的生物学问题,例如染色体数目是否与生物的功能具有相关性?以及染色体的数目是否具有可变性?相对于单个染色体,多个染色体对于真核细胞有何优势?限于技术的障碍,这些从未能够进行实验验证。
2008年,赵国屏参与中科院关于中国科技五十年发展路线图的编撰工作,负责“生命起源、进化与人造生命”部分。看到合成生物学将会给生命科学带来的颠覆性变革,赵国屏向中科院提出申请,以上海植物生理生态研究所分子微生物实验室为基础,成立了国内第一个“合成生物学重点实验室”。
实验室成立2年后的2011年,曾师从斯坦福大学基因克隆创始人之一斯丹利o科恩(Stanley N. Cohen)教授、38岁即获得国家自然科学基金委“杰青”资助的覃重军,从链霉菌研究开始向微生物染色体合成、改造、重编程方向转型。
曾经对原核生物驾轻就熟的覃重军随后大胆假设:真核生物是否也能像原核生物一样,用一条线型染色体装载所有遗传物质并完成正常的细胞功能?
假设之后,覃重军团队将目标锁定在酿酒酵母身上。酿酒酵母是一种模式单细胞真核生物,每个单倍体细胞内包含有16条线型染色体,每条染色体的基因组大小从230kb到1500 kb不等。
赵国屏表示,“从和我们实验的相关性来说,酵母首先是一种单细胞真核生物,有16条染色体,是典型的多染色体真核生物。此外,和大部分真核生物不一样的是,酵母染色体上仅有1个着丝粒,可以使得我们的工作相对简单。”
随后,覃重军等人“工程化精准设计”了定制人造单染色体酵母的指导原则以及理性分析、实验设计、工程化推进的总体方案。2013年开始,酵母染色体的融合工作启动。
15轮融合创建简约版酵母
一条完整的真核线型染色体,通常包含一个用于染色体分离的着丝粒和两个用于保护染色体末端的端粒。
为实现2条染色体的融合,不仅仅需要将2条染色体的2个端粒去除后相互连接起来,同时还需要将2条染色体中1条的着丝粒去除,从而保证染色体在细胞分裂过程中正常的分离。
论文中提到,在染色体融合操作中,需遵循一些标准和原则。为形成遗传稳定的融合染色体和避免双着丝粒染色体的形成,每次融合过程需同时去除1个着丝粒和2个端粒。研究团队用CRISPR–Cas9系统和酵母强大的同源重组活性开发了一种精确的染色体融合方法。
最后剩下的唯一1个着丝粒的位置大致要处于最后一条染色体的中间,从而保持染色体两臂平衡。同时,每个着丝粒和端粒的去除都要避免影响相邻基因,和端粒相关的超过2kb的长段重复序列需删除,避免在错误位点潜在的同源重组。
此外,染色体融合的顺序是随机的。先导实验表明,8对染色体随机融合都能成功,最终获得的菌株和野生型酵母菌株一样生长强劲,暗示酵母细胞可以适应2条染色体的随机融合。
在上述原则下,研究团队将VII染色体和VIII染色体首先融合,获得的酵母菌株命名为SY0。在融合过程中,VII染色体右臂的端粒和与端粒相关的长段重复序列被去除,VIII染色体左臂的端粒和与端粒相关的长段重复序列也被去除,同时VIII染色体的着丝粒被去除。
在同样的融合策略下,进行了15轮染色体端-端融合,最终获得酵母SY14菌株,仅含有1条巨大的线型染色体。
从2013年实验正式启动到酵母SY14菌株的成功获得,研究团队历经4年时间。
值得一提的是,从融合顺序来说,相比于覃重军等人的融合,杰夫o博克团队采用的方式略有差异。
杰夫o博克团队首先将所有的小染色体融合到了一起,获得带有12条染色体的酵母。随后通过进一步的融合,获得带有8条染色体的酵母。依次类推,最终获得了带有两条染色体的酵母。
在整个染色体融合过程中,杰夫o博克团队始终保证所获得的染色体在长度上是接近的。不过,在最后一步将2条染色体融合成一条的过程中,尽管经过了很多次的尝试,他们始终无法获得存活的,仅有1条染色体的细胞。
戴俊彪表示,杰夫o博克团队无法将两条染色体融合成一条的原因依然未知,也许通过比较带有两条和一条染色体酵母的差异,可以帮助解决这个问题。
覃重军则着重提到,“除了端粒、着丝粒,我们还把其中一些重复序列去掉了。另外,我们曾经也出现染色体融合之后酵母就不生长的情况,核查之后发现还是在操作上出现了误差,把着丝粒附近重要的基因损伤了。”这些或许是染色体融合成功与否的关键。
人工改造的简约版生命依旧可以存活
成功获得SY14菌株之后,覃重军团队进一步与合成生物学重点实验室赵国屏研究组、中科院生物化学与细胞生物学研究所周金秋研究员研究组、武汉菲沙基因信息有限公司及军事医学科学院赵志虎研究员等团队合作。
合作团队随后深入鉴定了SY14的代谢、生理和繁殖功能及其染色体的三维结构。
研究团队通过对创建的带有1条染色体的菌株进行分析,发现染色体数目减少后的细胞在形态上和带有16条染色体的野生型类似,在生长上仅出现较小的差异。染色体数目的减少仅导致少量的基因表达发生差异。
“从单独的生长、繁殖来说基本上是正常的,繁殖很多代也很稳定。明显的问题是把带有1条染色体的菌株和野生型的酵母细胞混合在一起培养,一代一代传代之后会发现,含有16条染色体的野生型酵母会越来越多,只有1条染色体的酵母会越来越少。”覃重军表示。
上述现象意味着,在自然竞争的状态下,带有1条染色体的人工改造过的酵母菌株相对于野生型是弱势的。
另外,染色体融合后存在的最明显的变化是染色体的三维结构。

野生型酵母染色体在细胞核中可以形成较为稳定的三维结构,其特征是所有的着丝粒会聚集在一起,位于细胞核的一端。而所有染色体短臂的端粒和长臂的端粒都会聚集在一起,位于细胞核的核膜附近。
人工创建的单条线型染色体的三维结构则因着丝粒、端粒等的大量去除发生了巨大变化。论文中提到,由于失去了所有和着丝粒相关的染色体间相互作用、大部分和端粒相关的染色体间相互作用,以及67.4%的染色体内的相互作用,16条天然线性染色体融合到单个染色体中导致了染色体的整个三维结构发生了显著变化。
该项工作表明,天然复杂的生命体系可以通过人工干预变简约,自然生命的界限可以被人为打破,甚至可以人工创造全新的自然界不存在的生命。
赵国屏认为,这项工作的意义,首先证明带有1条染色体的酵母和野生型并没有太大的差别,仅有一条染色体的酵母是可以存活的。
“第二点,染色体融合之后最大的改变是染色体三维结构的变化,此前认为染色体的三维结构变化会很大地影响生物体发挥功能,但现在看来没有那么大的影响。”赵国屏表示,“第三点是从进化上来说,研究证明了1条染色体的真核细胞是可以存在的,但它相比16条染色体的酵母还是有缺陷,这或许能解释为什么在真核生物进化的过程中,我们现在看到的几乎都是多染色体。”
赵国屏强调,基于合成生物学的研究实际上就相当于“建物致知”,“我们通过建设一个物品来增加我们的认识。”
值得一提的是,酿酒酵母通常还是研究染色体异常的重要模型,其1/3基因和具有23对染色体的人类基因同源。覃重军等人的创建的简约版酵母将来或为众多研究课题提供模型。
以端粒为例,端粒是线型染色体末端的保护结构,人类的过早衰老与染色体的端粒长度直接相关。随着细胞分裂次数的增加,端粒的长度逐渐缩短,当端粒变得不能再短时,细胞就会死亡。此外,端粒的缩短还与许多疾病相关,包括基因突变,肿瘤形成等。
与天然酵母的32个端粒相比,覃重军等人人工创造的单条线型染色体仅有2个端粒,为研究人类端粒功能及细胞衰老提供了很好的模型。
赵国屏介绍,未来研究团队会围绕染色体结构功能进一步研究。
戴俊彪也提到,带有1条或者2条染色体的酵母,可以作为一个新的研究平台,增进我们对染色体重组、复制和分离机制的解析,具有重要的意义。此外,两项研究的结果也说明酿酒酵母对染色体的长度没有限制(至少可以长达12Mbp),这为利用酵母构建高等生物的新染色体提供了理论依据。